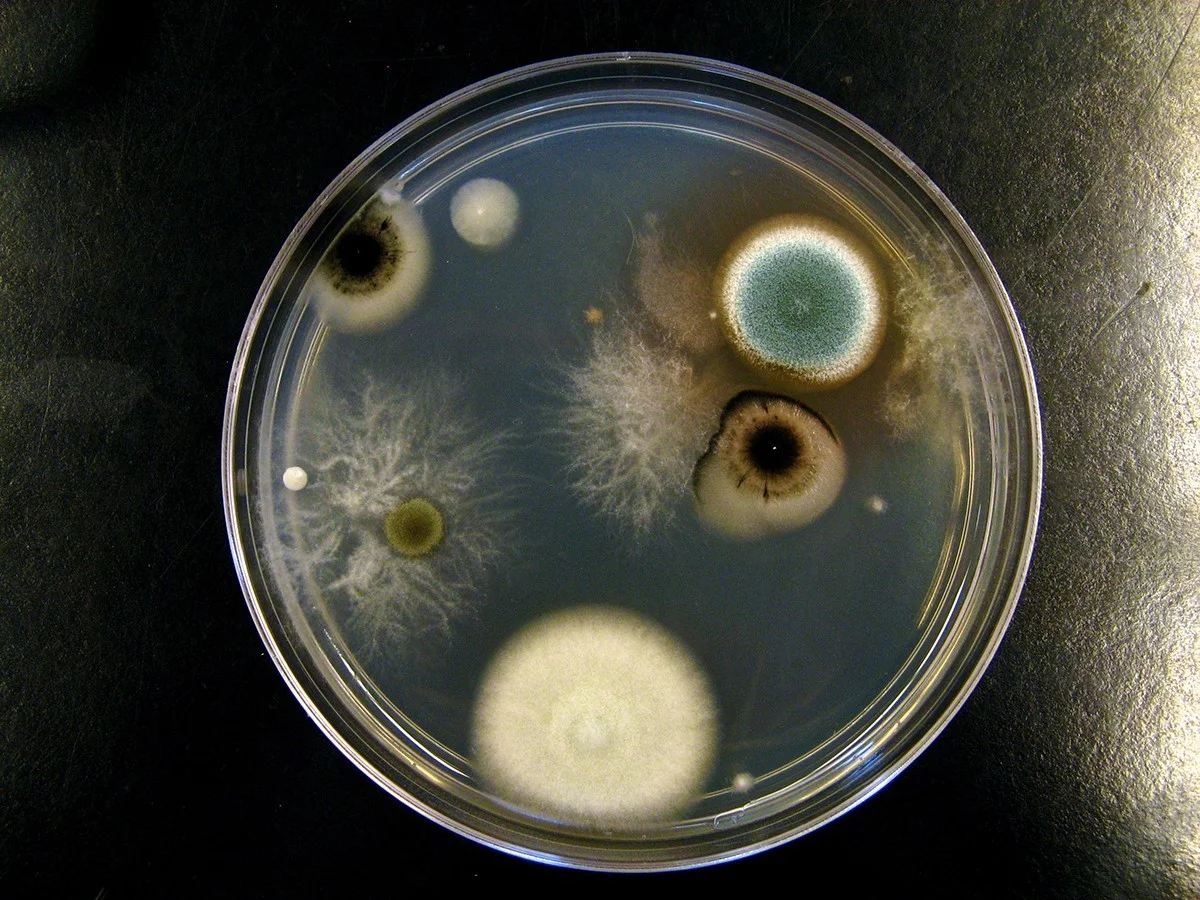
Zout op je vochtvlek: waarom dit beter werkt dan dure schimmelbestrijders - image 1

Je ziet een donkere vlek op de muur en meteen stijgt je hartslag — schimmel, weer een grote, dure oplossing. Veel mensen grijpen naar prijzige sprays of een spoedklus van de bouwmarkt, terwijl er een simpele, goedkope oplossing in je keukenkastje ligt.
Ik merkte dit zelf na een weekend-klussen in mijn jaren-30 huis: zout werkte sneller dan de meeste middelen uit de winkel en zonder chemische dampen in de kamer. Lees dit nu, want de herfst is dichtbij en natte muren worden alleen maar hardernekkiger.
Waarom zout vaak beter werkt dan dure schimmelspuitjes
Het klinkt bijna te simpel, maar er zijn concrete redenen waarom zout vaak voldoende is voor die ene vochtvlek:
- Zout trekt vocht aan en creëert een minder gunstige omgeving voor schimmel. Het droogt en remt groei.
- Het is extreem goedkoop: een kilo keukenzout kost je meestal minder dan €1 bij Albert Heijn, Jumbo of Lidl.
- Geen agressieve chemicaliën in huis — goed nieuws als je kinderen of huisdieren hebt.
- Direct zichtbaar effect binnen 24–72 uur bij oppervlaktevocht.
- Geen dure aanschaf van speciale schimmelmiddelen die vaak meerdere keren herhaald moeten worden.
Hoe zout werkt — zonder wetenschappelijke woordbrij
Stel je voor: schimmel houdt van een natte, zachte omgeving. Zout zuigt als een spons aan het oppervlak, maakt het droger en verandert het watergehalte. Minder water = moeilijke leefomstandigheden voor schimmel. Het is niet magisch, maar wel logisch.
Wanneer zout wél en wanneer zout niet genoeg is
In mijn praktijk met kleine klussen thuis zag ik dat zout uitstekend werkt bij oppervlakkige vochtplekken en beginnende schimmel. Maar er zijn grenzen.
- Gebruik zout als het gaat om kleine, lokale vlekken op pleisterwerk of achter schilderwerk.
- Laat professionele hulp komen bij doorlopende lekkages, optrekkend vocht of zwarte schimmel die terugkomt — dit zijn vaak structurele problemen.
- Bij meubels of textiel werkt zout tijdelijk, maar vaak is wassen of vervangen nodig.
Stap-voor-stap: zo pak je die vochtvlek aan met zout
Ik heb dit meerdere keren zelf uitgevoerd — eenvoudige materialen, kort resultaat. Volg deze stappen precies.
- Materialen: keukenzout of grof zeezout (AH, Jumbo), plastic handschoenen, stofmasker, zachte borstel, stofzuiger, doek.
- Stap 1 — Veiligheid: draag een stofmasker en handschoenen als er schimmel zichtbaar is. Open een raam voor ventilatie.
- Stap 2 — Schoonmaken: borstel loszittende schimmel en verf weg en zuig het op met de stofzuiger (met HEPA-filter als je die hebt).
- Stap 3 — Drogen: dep het oppervlak licht met een droge doek zodat er geen plaswater meer is.
- Stap 4 — Zout aanbrengen: strooi een dunne laag zout (3–5 mm) over de vochtvlek. Voor textiel: strooi op een plastic board en leg het meubel erop.
- Stap 5 — Wachten: laat het zout 24–72 uur inwerken. Bij hardnekkige plekken herhaal je dit 2–3 dagen.
- Stap 6 — Opruimen en nazorg: zuig het zout op of veeg het weg en controleer of de vlek lichter is. Overweeg een anti-schimmel primer vóór opnieuw schilderen.
Een bonushack: combineer zout met andere betaalbare middelen
- Voor sterk vocht: gebruik calciumchloride (bekend van “vochtvreters” in bouwmarkten) — dat trekt veel meer vocht aan dan keukenzout.
- Voor geur en extra reiniging: mix een eetlepel zuiveringszout (baking soda) met zout voordat je het aanbrengt.
Veelgemaakte fouten (die ik ook maakte)
Ik probeerde het ooit op een natte plek boven een badkamer zonder de oorzaak te verhelpen — zonde van het zout en frustrerend. Let op deze valkuilen:

- De oorzaak niet oplossen — zout is een tijdelijke remedie, geen structurele fix.
- Te dikke zoutlagen gebruiken — dat kan korstvorming geven en de verf beschadigen.
- Direct overschilderen zonder goed drogen — de vlek komt terug.
Praktische tips voor Nederlandse huizen
Ons klimaat in Nederland (vochtig en regenachtig, zeker in herfst en winter) maakt snelle actie belangrijk. Hier wat herkenbare, bruikbare tips:
- Koop gewoon keukenzout bij Albert Heijn, Jumbo of Lidl — goedkoper dan specialistische middelen.
- Voor huizen met slechte ventilatie: zet een elektrische luchtontvochtiger of vochtvreter (verkrijgbaar bij Gamma, Praxis) in de ruimte.
- Controleer dakgoten en afvoeren na herfststormen — veel vochtplekken ontstaan door verstopte goten.
Belangrijk: als de vochtplek terugkomt of uitgebreid is, bel dan een professional. Je wilt geen verborgen schade die later veel meer kost in euro’s.
Kort en krachtig
Zout is goedkoop, eenvoudig en vaak verrassend effectief tegen oppervlakkige vochtvlekken en beginnende schimmel. Ik gebruikte het zelf meerdere keren en het scheelde me kosten en onaangename chemische luchtjes. Maar wees realistisch: soms is de oorzaak groter dan een zakje zout.
Heb jij zout al eens geprobeerd tegen een vochtvlek? Deel je ervaring of foto hieronder — misschien bespaar jij iemand anders een dure aankoop.